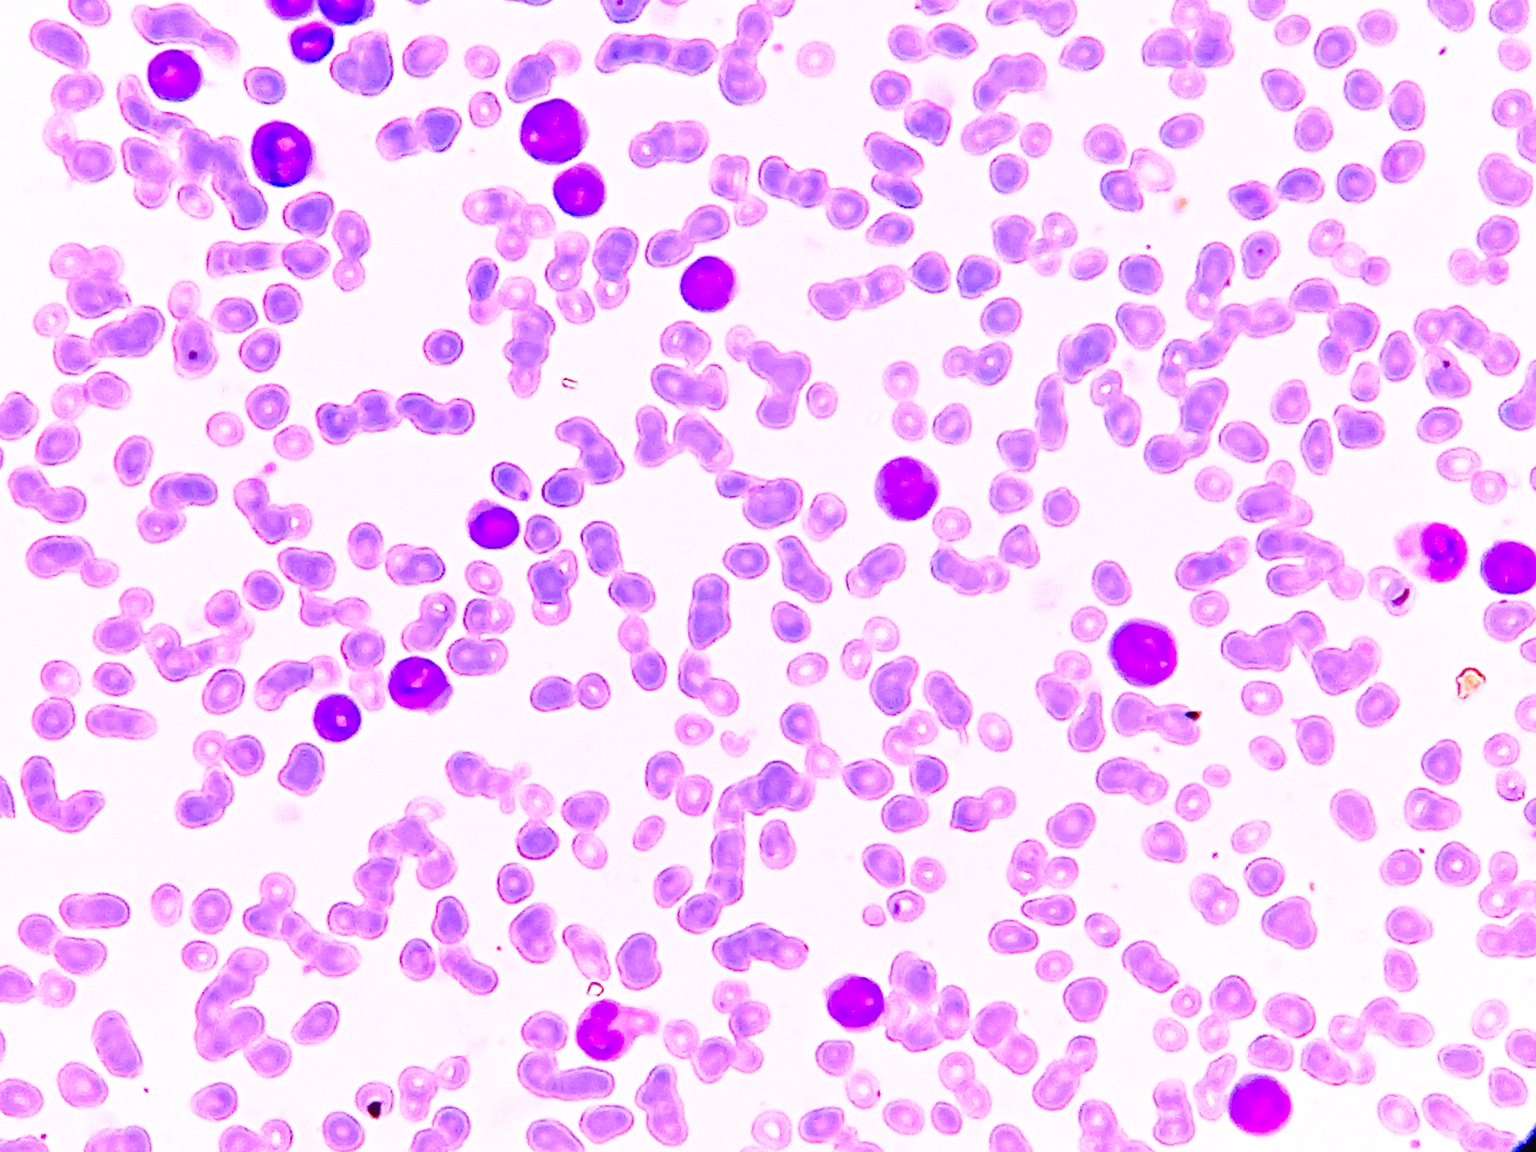

Biotechnology
搜索文档
QIAGEN N.V. to Release Results for Q4 2025 and Hold Webcast
Businesswire· 2026-01-19 22:56
公司财务信息发布安排 - 凯杰公司计划发布2025年第四季度业绩报告 [1] - 新闻稿发布时间为2026年2月4日法兰克福时间22:05后 即纽约时间16:05后 [1] - 业绩电话会议将于2026年2月5日法兰克福时间15:30举行 即纽约时间09:30 [1] 投资者沟通渠道 - 投资者可通过电话拨入或注册回拨服务参与业绩会 服务在会议开始前15分钟开放 [2] - 提供美国、英国、德国的拨入号码 会议ID为3382302 [2] - 提供音频网络直播及后续重播链接 [3] 公司业务概况 - 凯杰公司是样本到洞察解决方案的全球领导者 专注于从生物样本中提取和分析分子信息 [3] - 公司业务涵盖样本技术、检测技术、生物信息学和自动化解决方案 以提供可操作的见解 [3] - 公司服务全球超过500,000名客户 涵盖生命科学和分子诊断领域 [3] - 截至2025年9月30日 公司在全球超过35个地点拥有约5,700名员工 [3]
Top 10 Oncology Stocks to Buy Now
Insider Monkey· 2026-01-19 21:34
In this article, we will be taking a look at the Top 10 Oncology Stocks to Buy Now.The oncology market in the United States was estimated at $81.34 billion in 2025 and is expected to reach $211.78 billion by 2034 with a compound annual growth rate of 11.75%. This growth can be mainly explained by the rising cancer rates and the higher expectations of personalized, more effective, and sophisticated treatment.Targeted treatments and monoclonal antibodies remain the top sectors of the US oncology industry, wi ...
Why I’m Selling Sellas Life Sciences Ahead Of The REGAL Reveal (NASDAQ:SLS)
Seeking Alpha· 2026-01-19 21:07
文章核心观点 - 文章内容旨在提供信息 不构成详尽的公司分析或个性化的投资建议 [2] - 文章中的预测和观点基于作者分析 反映概率性方法而非绝对确定性 [2] - 读者在做出任何投资决策前 需独立核实信息并进行自身研究 [2] 分析师与平台披露 - 分析师声明未持有所提及公司的任何股票、期权或类似衍生品头寸 且在接下来72小时内无启动此类头寸的计划 [1] - 分析师未因撰写本文获得任何公司补偿 与所提及股票的公司无业务关系 [1] - 分析师为第三方作者 可能并非由任何机构或监管机构许可或认证 [3] - 发布平台并非持牌证券交易商、经纪商、美国投资顾问或投资银行 [3]
Guardant Health Announces Multi-Year Strategic Collaboration Agreement with Merck to Develop Companion Diagnostics and Commercialize New Cancer Therapies Using Guardant Infinity Smart Platform
Businesswire· 2026-01-19 21:05
PALO ALTO, Calif.--(BUSINESS WIRE)--Guardant Health, Inc. (Nasdaq: GH), a leading precision oncology company, today announced a multi-year collaboration with Merck, known as MSD outside the United States and Canada, to support the development and commercialization of Merck's oncology portfolio using the Guardant Infinityâ"¢ Smart platform. Use Guardant's portfolio of liquid and tissue biopsy tests as clinical trial enrolling assays in Merck's global clinical studies, Evaluate opportunities to develop novel ...
Morgan Stanley Backs Tenaya Therapeutics (TNYA) as SMID-Cap Biotech Primed to Outperform in 2026
Yahoo Finance· 2026-01-19 21:01
Tenaya Therapeutics Inc. (NASDAQ:TNYA) is one of the overlooked growth stocks to buy. On January 8, Morgan Stanley lowered the firm’s price target on Tenaya Therapeutics to $2 from $5 and kept an Overweight rating on the shares. In a sector outlook note, the firm predicted that the US small-to-mid cap biotech stocks will continue to outperform in 2026. This bullish view is driven by commercial-stage companies transitioning from capital consumers to producers and a looming patent cliff that is currently thr ...
Why Tech Fund Manager Cathie Wood Sees a ‘Golden Age’ for US Stocks Ahead
Investopedia· 2026-01-19 21:00
市场前景与宏观环境 - ARK Invest首席执行官Cathie Wood认为未来三年市场可能进入“黄金时代” [1] - 预计在特朗普政府下更宽松的商业环境将支持技术投资 从而释放美国企业增长 [1] - 预计降息、减税和放松管制可能推动股市上涨 并使美国名义GDP年增长率在未来几年加速至6%至8% [2] 投资主题与行业关注 - 公司专注于投资引领行业颠覆性创新的企业 在科技投资界拥有大量追随者 [3] - 预计美国最大公司的巨额资本支出 加上AI等技术进步将带来生产率提升 且运行模型的成本预计将下降 [3] - 认为AI、机器人、能源存储、区块链和生物技术等领域的发展 可能将生产率增长推至可持续的新高并创造显著财富 [4] 公司产品与表现 - 旗舰产品ARK创新ETF(ARKK)的最大持仓包括特斯拉、Crispr Therapeutics、Roku和Coinbase 体现了公司在相关领域的投资布局 [5] - 去年ARK创新ETF(ARKK)录得总回报率约35% 表现优于标普500指数18%的涨幅 [5]
ALPS Medical Breakthroughs ETF (SBIO US) - Portfolio Construction Methodology
ETF Strategy· 2026-01-19 20:35
ALPS Medical Breakthroughs ETF (SBIO US) – Portfolio Construction MethodologyThe underlying S-Network Medical Breakthroughs Index provides exposure to US-listed biotechnology developers in the small- and mid-cap bracket with late-stage drug pipelines. The universe is companies listed on a US exchange and principally engaged in biotechnology. Eligible constituents must have market cap between 200 million and 5 billion USD, sustain 90-day ADTV above 1 million USD, have at least one drug in Phase II or Phase I ...
My Forever Portfolio: 5 Stocks I Don't Plan on Ever Selling
The Motley Fool· 2026-01-19 17:44
投资策略 - 作者从频繁交易转向买入并持有策略后 投资回报显著改善 [1] - 当前仅在公司初始投资前提发生变化时才会卖出股票 [2] 亚马逊 (AMZN) - 公司秉持“永远是第一天”的文化 持续寻找新机会 [3] - 亚马逊云服务在2025年前九个月创造了930亿美元销售额 占公司总运营收入的59% [4] - 公司当前市值为2.6万亿美元 毛利率为50.05% [6] - 未来增长机会包括卫星互联网服务和消费机器人等潜在巨大市场 [6] 苹果 (AAPL) - 公司构建了以iPhone为核心的强大产品与服务生态系统 [7] - 被描述为“可能是世界上最好的企业” [7] - 未来有望在AI眼镜市场成为赢家 并预计在6G无线网络推出后的十年内创造巨大收入 [8] 伯克希尔·哈撒韦 (BRK.A / BRK.B) - 尽管创始人已不再担任CEO 但其商业和投资哲学在公司内依然稳固 [9][10] - 新任CEO的言论与创始人的理念非常相似 [10] - 公司当前市值为1.1万亿美元 毛利率为24.85% [11][12] - 其多元化的内部业务组合及上市公司股权投资是过去成功的关键 并预计将持续推动未来成功 [12] 直觉外科 (ISRG) - 作为机器人手术系统先驱 公司将受益于全球人口老龄化带来的手术量激增 [13] - 技术进步是另一个对公司至关重要的趋势 [13] - 基于现有获批产品 公司估计约有800万例手术适合使用其手术机器人 而随着正在开发的产品和审批推进 该数字将跃升至2200万例 [14] 福泰制药 (VRTX) - 公司在治疗囊性纤维化根本原因方面实际上拥有垄断地位 并通过新药Alyftrek进一步巩固了领导地位 [16] - 公司已通过基因编辑疗法Casgevy和非阿片类止痛药Journavx将业务扩展至囊性纤维化之外 [16] - 公司当前市值为1120亿美元 毛利率高达86.29% [17][18] - 预计其药物povetacicept将获得治疗IgA肾病的监管批准 该疾病在欧美影响33万名患者 规模几乎是囊性纤维化患者群体的三倍 同时对其APOL1介导的肾病药物inaxaplin和1型糖尿病疗法zimislecel也抱有成功预期 [18] - 预计公司将继续运用其科学专长来治疗甚至治愈最具挑战性的疾病 [19]
BioNxt Reports Successful Final In-Vivo Dosing Study Results Supporting Superior Bioavailability of Cladribine Sublingual ODF
Accessnewswire· 2026-01-19 16:05
VANCOUVER, BC / ACCESS Newswire / January 19, 2026 / BioNxt Solutions Inc. ("BioNxt" or the "Company") (CSE:BNXT)(OTCQB:BNXTF)(FSE:BXT), a bioscience innovator specializing in advanced drug delivery systems, is pleased to announce that it has completed and received preliminary results from its comparative pharmacokinetics ("PK") large-mass animal study in pigs. The study measured how efficiently cladribine is absorbed into the bloodstream over time and compared BioNxt's proprietary orally dissolving film (" ...
Nature Cancer:浙江大学梁廷波/平渊团队合作开发新型溶瘤病毒平台,克服溶瘤病毒全身给药难题
生物世界· 2026-01-19 16:00
为应对上述挑战,溶瘤病毒的全身给药,已成为改善难以触及的癌症临床疗效的主要研究方向;然而,此 前的研究报告指出,溶瘤病毒全身给药存在一些问题,包括被预先存在的抗病毒中和抗体迅速清除以及潜 在的全身毒性。 尽管提高溶瘤病毒的剂量能够提升其向肿瘤的递送效率,但这也带来了潜在的全身毒性风 险,可能导致严重的副作用甚至患者死亡。 因此,迫切需要开发一种能够增强 溶瘤病毒向肿瘤的递送能力的同时 降低给药剂量的平衡方法。 撰文丨王聪 编辑丨王多鱼 排版丨水成文 溶瘤病毒 ( Oncolytic Viruse, OV) 是癌症治疗中一种很有前景的疗法。这些具有复制能力的病毒既能 感染正常细胞也能感染肿瘤细胞,但它们在肿瘤细胞中选择性复制,从而引发抗肿瘤反应。基于单纯疱疹 病毒 (HSV) 的首个获美国 FDA 批准的溶瘤病毒疗法 Imlygic 瘤内注射治疗黑色素瘤取得了成功,但其 在深部或转移性肿瘤中的治疗效果仍有限。 在这项最新研究中,研究团队开发了基因工程改造的、免疫兼容的细胞膜,其表达 嵌合抗原受体 (CAR) 以被 溶瘤病毒 (OV) ,从而构建了一种肿瘤靶向的溶瘤病毒递送平台—— iNV-GOV ,该平台既能保 ...